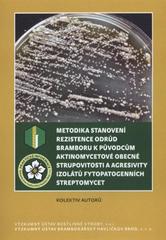
kniha Metodika stanovení rezistence odrůd bramboru k původcům aktinomycetové obecné strupovitosti a agresivity izolátů fytopatogenních streptomycet, Výzkumný ústav rostlinné výroby 2011

Metodika stanovení rezistence odrůd bramboru k původcům aktinomycetové obecné strupovitosti a agresivity izolátů fytopatogenních streptomycet
kolektiv autorů [Iveta Pánková ... et al.]
| rok vydání | 2011 | ||||||||||||||
|---|---|---|---|---|---|---|---|---|---|---|---|---|---|---|---|
Zobrazit více
|
|||||||||||||||
Prodám tuto knihu
Tuto knihu nikdo nenabízí
Nabízení knih k prodeji je dostupné pouze registrovaným uživatelům s ověřeným číslem mobilního telefonu. Zaregistrovat
Sháním tuto knihu
Knihu zatím nikdo neshání
Sháním tuto knihu
Jakmile knihu někdo nabídne, dáme vám vědět.
(reklama)
Recenze
Přidejte svou recenzi a pomozte dalším čtenářům
Tuto knihu zatím nikdo nekomentoval.
Pro přidávání komentářů se prosím přihlašte.
Nahlásit chybu u této knihy
Antikvariát Restorio
(reklama)

















































